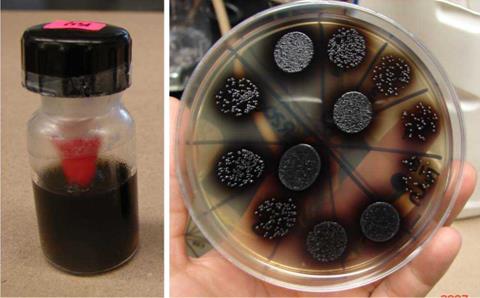

Introducción
El objetivo principal, una vez concluido el tratamiento de conductos radiculares es obtener y establecer un sellado hermético, el cual es considerado uno de los principales requisitos para el éxito de la terapia endodóncica a largo plazo; lo que hace relevante la evaluación de la calidad del sellado en la obturación coronal con estudios de filtración "ex vivo".1
La filtración coronal del sistema de conductos radiculares (SCR) ha sido considerada una causa importante del fracaso en la terapia del tratamiento de conductos. Una buena restauración coronal aunada a un buen tratamiento de conductos da como resultado un mayor porcentaje de éxito en el tratamiento.1
En ocasiones se pueden observar pacientes que se presentan a la clínica con tratamiento de conductos expuestos al medio bucal, a veces con vestigios de obturación provisional o sin ella, lo que conlleva a la contaminación y a la repetición del tratamiento de conductos. Siendo una preocupación para el profesional la restauración de dicho órgano dental; se han realizado numerosos estudios de filtración coronal como un factor importante en el fracaso del tratamiento de conductos.
Balto2 reportó que el IRM, Cavit y Dyract, mostraban filtración cuando se usaban como materiales de restauración provisional en un mes. Esta filtración se extiende de forma completa en toda la longitud del sistema de conductos radiculares. Roghanizad3 reportó que 3 mm de Cavit, TERM o amalgama colocados en la entrada del conducto radicular mostraban menor filtración que el grupo control positivo, que no presenta material sellador en la entrada del conducto cuando fueron expuestos por dos semanas con la técnica del azul de metileno. Pissano4 colocó 3.5 mm de Cavit, IRM o SuperEBA en la entrada de conductos obturados y estos dientes fueron expuestos a la saliva por 90 días y la evidencia de filtración se indicó por medio de la turbidez del medio, todos los dientes filtraron en cuarenta y nueve días.
Los estudios de Ray y Trope5 (1995) y de Kirke-vang6 (2000) encuentran que la restauración coronal tiene mayor importancia que la obturación del sistema de conductos radiculares. Tronstad y cols7 (2000), encuentran que la calidad del tratamiento de conductos es más importante. Para Hommez y cols.1 (2002) ambos aspectos son igualmente importantes.
Adib y cols.8 (2004), Chávez de Paz y cols.9 (2004), concuerdan con los estudios de Nair10 (1999) y mencionan que en caso de recontaminación del SCR obturados se aíslan principalmente anaerobios gram positivos en dientes con periodontitis apical persistente y filtración coronal, siendo el Enterococcus faecalis uno de los más predominantes.
De acuerdo al fabricante, el Guttaflow® está compuesto de aceite de silicona, aceite de parafina, catalizador platino, dióxido de zirconio, nano plata (conservador), colorante, ofrece buenas propiedades de sellado, se distribuye de forma homogénea después de la mezcla, fluye fácilmente en conductos laterales y túbulos dentinarios, es radio opaco, sin contracción, presenta una ligera expansión de 0.02%, tiene un tiempo de trabajo de 10 a 15 minutos y un tiempo de fraguado de 25 a 30 minutos. Es fácil de manejar y de usar, no requiere compactación, es fácil de remover cuando son necesarias repeticiones de tratamiento. Presenta gran fluidez y gran adaptabilidad al conducto.11
El inconveniente que puede presentar el material es que al ser una pasta siempre corremos riesgo de tener huecos en la obturación y provocar una sobreobturación. A través del contacto con fluidos, los materiales tienden a disolverse a través de los años, creando así espacios que permiten la colonización de bacterias. La mayoría de los selladores de conductos tienen cierta solubilidad a diversos grados. La solubilidad de Guttaflow es virtualmente de cero.11
Las pruebas acorde a la Norma ISO 6876:2001 muestran una solubilidad de 0.0%, resultando en una dimensión estable. En los tejidos no se muestran señales de inflamación y muestran una morfología y posición normal de los fibroblastos.11,12
Con el advenimiento de mejores materiales restaurativos en odontología, se torna relevante su estudio para evaluar su capacidad de sellado en la entrada de los conductos radiculares para prevenir la filtración bacteriana.
Con el desarrollo de la tecnología, 3M ESPE presenta en el mercado a la resina Z350, la cual parece tener mejores propiedades en cuanto a filtración y a resistencia con una aparente mejor adhesión al diente. Su manejo es sencillo, el costo del material para colocarlo como un doble sellado antes de una restauración final de un diente con tratamiento de conductos es mínimo, porque sólo se utiliza una pequeña porción de resina, es mayor si se compara con el ionómero modificado con resina, pero si estos materiales prueban ser mejores que el Guttaflow® en cuanto a filtración, podemos elevar el pronóstico de nuestros tratamientos y cada vez hacer un mejor tratamiento de conductos con resultados más predecibles.
El propósito de este estudio fue determinar, si después de tres meses de exposición, existe filtración coronaria con Enterococcus faecalis en dientes de humanos obturados con Guttaflow® sin sellado coronal y si existen o no diferencias significativas entre dientes de humanos obturados con Guttaflow® y sellado coronal con IRM (Denstply) como material de obturación provisional, dientes de humanos obturados con Guttaflow® y sellado coronal con Vitremer (3M ESPE), dientes de humanos obturados con Guttaflow® y sellado coronal con resina Z350 (3M ESPE).
Métodos
Preparación de las muestras. Ochenta y seis dientes anteriores humanos extraídos fueron utilizados en este estudio. Los dientes se almacenaron en solución salina al 0.9% para mantenerlos hidratados durante todo el experimento. El ligamento periodontal se removió de los dientes con curetas y se mantuvieron en hipoclorito de sodio a 5.25% por 30 minutos.
Los dientes fueron seccionado a 2 mm de la unión amelocementaria (dejando un espesor de esmalte) sin caries obteniendo una longitud de 17 mm en promedio para su estandarización radicular y fueron evaluados con el microscopio de luz (Carl Zeiss, modelo Axiotech) para eliminar la posibilidad de que estén fisurados o fracturados, además fueron radiografiados en el plano mesiodistal y bucolingual para determinar la existencia de un solo conducto radicular. La preparación del conducto y la obturación fue hecha por el mismo operador.
El acceso al sistema de conductos radiculares fue realizado con fresas de carburo Brasseler esféricas #4 y 6 de alta velocidad bajo copiosa irrigación.
La longitud de trabajo fue establecida a 1 mm corto del foramen apical una vez patentizado con una lima #10 y después de calibrar el conducto con la última lima ajustada y no pase el foramen al hacer mínima presión.
El ensanchado coronal se realizó con fresas Gates Glidden #2 y #3 (Maillefer) y abridores de conducto con conicidad 0.10, 0.08 (sistema K3 Sybron-Endo).
Los conductos fueron instrumentados con limas rotatorias K3 sistema VTVT de níquel titanio (Sybron-Endo) utilizadas según Fred Barnett estandarizando el diámetro del conducto hasta un diámetro apical # 45, conicidad 0.02.
El motor utilizado fue NSK-Endomate DT (Sybron-Endo) con un contra-ángulo 10:1.
Se introdujo lima K3 de conicidad 0.10 punta 0.25 hasta la longitud en donde se sintió resistencia, a una velocidad de 350 rpm usando poca presión y movimientos de entrada y salida (no se utilizó más de 6 segundos dentro del conducto).
Se introdujo lima K3 de conicidad 0.08 punta 0.25 a resistencia, a la misma velocidad y los mismos movimientos.
Se introdujo lima K3 de conicidad 0.06 punta 0.35 hasta donde se sienta resistencia y a 350 rpm, usando poca presión y movimientos de entrada y salida.
Se introdujo lima K3 de conicidad 0.04 punta 0.30 hasta sentir resistencia.
Se introdujo lima K3 de conicidad 0.06 punta 0.25 hasta sentir resistencia.
Se introdujo lima K3 de conicidad 0.04 punta 0.20 hasta sentir resistencia.
Se utilizó lima K3 de conicidad 0.04 punta 0.40 hasta llegar a la longitud de trabajo (lima que no forma parte del sistema VTVT).
El diámetro de ensanchado apical se llevó a una lima tamaño # 45, conicidad 0.02 para disminuir las variables de ensanchado apical.
Aproximadamente 2 mL de hipoclorito de sodio al 2.5% se utilizó como irrigación entre cada lima, como irrigación final 1 mL de Smear Clear al 17%, activándolo con el cono maestro por 1 minuto para asegurar la remoción del lodillo dentinario y posteriormente otra irrigación con gluconato de clorhexidina al 2% (Concepsis®-ultradent).
Los conductos se secaron con puntas de papel estériles Hygenic y los especímenes fueron esterilizados con óxido de etileno para eliminar la carga bacteriana. Los conductos se obturaron con Guttaflow® siguiendo las indicaciones del fabricante.11 Se eligió una cápsula y se activó el material comprimiendo la tapa verde que cubre la cápsula, se agitó la cápsula durante 30 s. triturando con frecuencia de oscilación de 2,000 -4,500 osc/min. Se retiró de la cápsula la punta de activación verde, se colocó en el dispensador, el material mezclado debe ser de color rosa, se empujó el cono maestro moviéndolo hacia arriba y hacia abajo dos veces para asegurarse del contacto completo entre el cono y la pared del conducto. A partir de la entrada del conducto se hizo un espacio de 4 mm con un condensador de Schilder para dar lugar al material de obturación provisional. La profundidad de la cavidad fue medida con una sonda periodontal desde la entrada del conducto. Se limpió la cavidad con alcohol para eliminar la liberación de oxígeno del hipoclorito de sodio y obtener mejor adaptación de las restauraciones provisionales a la estructura dentaria. Todos los dientes fueron instrumentados y obturados de la misma forma por un solo operador y los dientes fueron divididos al azar en 4 grupos de 20 dientes y 2 grupos control de 3 dientes cada uno:
Grupo 1: Obturados con Guttaflow® sin material provisional coronal (G) - 20 dientes sellados 3 mm antes de nivel apical con una capa de cera pegajosa y 3 capas de barniz de uñas.
Grupo 2: Obturados con Guttaflow® con material provisional coronal IRM (Denstply) (Z) -20 dientes sellados 3 mm antes del nivel apical con una capa de cera pegajosa y 3 capas de barniz de uñas.
Grupo 3: Obturados con Guttaflow® con material provisional coronal Vitremer (3M ESPE) (V) -20 dientes sellados 3 mm antes del nivel apical una capa de cera pegajosa y 3 capas de barniz de uñas.
Grupo 4: Obturados con Guttaflow® con material provisional coronal resina Z350 (3M ESPE) (R) -20 dientes sellados 3 mm antes de nivel apical con una capa de cera pegajosa y 3 capas de barniz de uñas.
Grupo 5: Control negativo-3 dientes-obturados con Guttaflow® y sellados a nivel apical con una capa de cera pegajosa y 3 capas de barniz de uñas incluyendo el foramen apical y la entrada del conducto.
Grupo 6: Control positivo-3 dientes- un cono de Guttaflow® colocado dentro del conducto sin sellador cubiertos con 3 capas de barniz de uñas dejando expuestos el foramen apical y la entrada del conducto.
Una capa de 4 mm de restauración provisional se colocó en cada uno de los grupos, excepto los grupos 1, 5 y 6.
Todos los dientes, una vez obturados y sellados coronalmente con el material provisional correspondiente, fueron esterilizados con óxido de etileno (en el Hospital Centro Médico siglo XXI) según Pashley13 en 1991.
Todos los dientes fueron colocados en tubos sellados y mantenidos en una incubadora a 37ο C durante una semana para asegurar el endurecimiento del cemento sellador.
Modelo de filtración. El modelo de filtración para el estudio consistió en un tubo cónico de plástico tipo «eppendorf» de 1.5 mL al cual se adaptó el diente de prueba para ser posteriormente colocado dentro de un frasco de vidrio de 12 mL de capacidad y en contacto con medio de cultivo que favorece el desarrollo de las bacterias filtrantes14( Figura 1 ).
El diente de prueba se adaptó al tubo eppendorf sellándose con cianoacrilato, cera pegajosa y barniz de uñas dejando libre de barniz los últimos 3 mm. Los dientes fueron esterilizados en óxido de etileno para eliminar bacterias remanentes.
Cada diente se colocó en un frasco de vidrio con aproximadamente 4 mL del medio de cultivo semisólido Enterococosel™ de BBL (medio de bilis esculina modificado específico para el desarrollo de Enterococos) permitiendo mantener la zona apical en contacto con el medio de cultivo contenido en el frasco. Para disminuir la difusión de oxígeno y evitar la sequedad del medio se colocó sobre éste una capa de 1 mL de aceite mineral.15 El tubo eppendorf fue sellado a la boca del frasco con cianoacrilato y la tapa del frasco fue sellada con Parafilm «M»™.
Preparación del inóculo de Enterococcus faecalis. La evaluación microbiológica se realizó en el Departamento de Salud Pública de la Facultad de Medicina. A partir de un cultivo puro de 24 h de la cepa de Enterococcusfaecalis ATCC 29212 (con un diámetro de 0.5 a 1 /µm) se preparó una suspensión bacteriana en solución salina isotónica correspondiente a 1.5 x 108 UFC/mL utilizando un colorímetro digital DENSIMAT (BioMérieux). Se inocularon 400 /µL de esta suspensión en el tubo Eppendorf que se encuentra en contacto con la entrada del conducto, la suspensión bacteriana fue cambiada cada dos días para mantener la viabilidad y concentración constante de Enterococcus faecalis durante el desarrollo del experimento. En el medio semisólido utilizado se observa un desarrollo positivo de Enterococcus faecalis cuando en el medio hay un ennegrecimiento gradual el cual es visible en la zona de filtración debido a la actividad metabólica sobre la esculina y su posterior reacción con el citrato férrico del medio. El uso del medio semisólido permite evaluar si el desarrollo de E. faecalis se realiza en la zona apical debido a la filtración o en la superficie del medio debido a la pérdida del sellado en el sistema.
Los 86 frascos con los dientes fueron mantenidos a 37οC en una incubadora de agitación a 125 rpm durante un periodo máximo de 12 semanas ( Figura 2).
Se observaron diario para evaluar zonas oscuras en la región apical de los dientes. Los frascos sospechosos fueron analizados por cultivo tomando una alícuota de 10 /µL de la zona de ennegrecimiento. Las alícuotas fueron sembradas en placas de agar sangre y agar bilis esculina de 24 a 48 h a 37°C para confirmar la presencia de Enterococcus faecalis en el medio inferior16( Figura 3).
Microscopia electrónica de barrido
A los tres meses, dos dientes de cada grupo experimental tomados al azar (G12, G15, Z16, Z19, V18, V20, R3, R18) fueron analizados en microscopia electrónica de barrido para determinar la presencia de «gaps » (espacios) y «tags » (uniones) entre el material de obturación y el conducto radicular. Los dientes fueron fracturados utilizando nitrógeno líquido y un cincel con punta cortante, una vez realizada una guía previa a la fractura.
Posteriormente se montan en porta-especímenes de aluminio pegándolas con adhesivo Temp-Fix para después colocarlas en un ionizador de oro por quince minutos con un voltaje de 2.4 kV y una corriente de 5 mA ( Figura 4).
Las raíces fueron analizadas en un microscopio electrónico de barrido (JEOL-JSM-5310LV del laboratorio de MEB de la Facultad de Ciencias de la UNAM) con un voltaje de aceleración 15 kV ( Figura 5).
Tinción de Brown/Brenn
A los tres meses, dos dientes filtrados de cada grupo (G2, G20, Z12, Z14, V7, V10) y un diente sin filtrar de cada grupo (G6, Z8, V8, R16) fueron analizados con la técnica de tinción Brown/Brenn para teñir bacterias y determinar la penetración de las mismas desde la entrada del conducto hasta el foramen radicular.
La técnica consistió en colocar los dientes inmersos en 10% de formalina neutral por un mínimo de 48 horas. Posteriormente las muestras son desmineralizadas en ácido fórmico/citrato sódico al 22.5% de 20 a 30 días. Posteriormente los especímenes se dejan lavando en agua corriente durante 12 a 24 horas y son deshidratados en grados ascendentes de etanol, limpiados con xilol y finalmente infiltrados y embebidos en parafina a 56oC, de acuerdo a los procedimientos estándar.
Los dientes fueron cortados longitudinalmente con un microtomo que realiza cortes de 4-5 mm; se realizaron secciones de corte consecutivas hasta que cada diente fue examinado, tomando precauciones durante los cortes del tercio apical para obtener secciones que incluyan el foramen apical.
Una técnica de tinción Brown/Brenn fue utilizada para pigmentar a las bacterias (Taylor17 1966) la cual fue usada en cortes seleccionados, los cuales son cubiertos con portaobjetos y examinados en el microscopio Olympus Ax70 modelo Provis en el Laboratorio de Microcine de la Facultad de Ciencias de la UNAM.
Análisis estadístico
El método de análisis utilizado fue una prueba no paramétrica denominada Kaplan-Meier conocido también como del «límite del producto».18,19 La característica distintiva del análisis es que la proporción acumulada que sobrevive se calcula para el tiempo de supervivencia individual de cada muestra y no se agrupan los tiempos de supervivencia en intervalos. Por esta razón es especialmente útil para estudios que utilizan un número pequeño de muestras. Se utiliza cuando la muestra es menor de treinta.
Fue utilizado el método Kaplan-Meier para estimar la «curva de supervivencia» de cada grupo experimental; la «muerte» del espécimen corresponde al tiempo en que la primera filtración bacteriana fue evidente.
Resultados
Los tres controles positivos utilizados filtraron a las 24 horas. Los controles negativos no presentaron filtración durante los 90 días de evaluación. Las diferencias estadísticas fueron observadas en los grupos experimentales Guttaflow (p < 0.2883), IRM (p < n/p), Vitremer (p < 0.0830) ( Figura 6 , Figura 7 y Figura 8).

Figura 6 Probabilidad de supervivencia Kaplan-Meier (dientes filtrados) del material Guttaflow. Representa la cantidad de especímenes filtrados durante el periodo experimental de 90 días.

Figura 7 Probabilidad de supervivencia Kaplan-Meier (dientes filtrados) del material IRM (dientes filtrados) Representa la cantidad de especímenes filtrados durante el periodo experimental de 90 días.

Figura 8 Probabilidad de supervivencia Kaplan-Meier (dientes filtrados) del material Vitremer. Representa la cantidad de especímenes filtrados durante el periodo experimental de 90 días.
Los primeros dientes en presentar ennegrecimiento obturados con Guttaflow (G) sin material provisional, 5 de 20 siendo G7, G20, G2, G13, G19 que corresponden al 25% de los dientes que filtraron, fueron al día 6, 17, 47, 61 de la exposición a Enterococcus faecalis, como se aprecia en los Cuadro I y Cuadro 2.

Cuadro I Recopilación de resultados de los grupos a los 90 días de exposición al Enterococcus faecalis.
Los primeros dientes en presentar ennegrecimiento con material provisional de IRM (Z), 2 de 20 siendo Z12, Z14 que corresponden al 10% de los dientes que filtraron, fueron al 6 día y a los 83 días a la exposición de Enterococcus faecalis. Las diferencias en la filtración bacteriana del grupo IRM en comparación con Vitremer y Guttaflow probablemente se deban a la capacidad bactericida que tiene el eugenol ( Cuadro I).
El grupo de Vitremer (V) no presentó filtración en el primer mes ( Cuadro II). Los primeros dientes en presentar ennegrecimiento con material provisional de Vitremer, 7 de 20 siendo V10, V19, V7, V17, V9, V6, V5 que corresponden al 35% de los dientes que filtraron, fueron al día 33, 34, 55, 80, 84, 88 de la exposición a Enterococcus faecalis. Podemos mencionar que es un buen material coronal provisional pero deberá ser usado como máximo un mes.
De los materiales provisionales, el que menos filtró fue la resina Z350 (R), 20 de 20 que corresponden al 100% de los dientes estudiados, en donde ninguna muestra presentó ennegrecimiento (filtración bacteriana) ( Cuadro I y Cuadro 2).
Los dientes enviados a microscopia electrónica fueron: G15, G12, Z16, Z19, V18, V20, R3, R18 en donde no se encontró la presencia de Cuadro «tags» y sí la presencia de «gaps» según se observa en la Figura 9.

Figura 9 Microfotografía tomada a 100 X (JOEL JSM- 5310LV) a muestra de Guttaflow (12) en tercio medio. GP = gutapercha, GF = Guttaflow, GAP = Espacio, D = dentina.
«Gaps » (espacios) que se observan en tercio cervical de la muestra de resina Z350 (3) y la dentina ( Figura 9a).

Figura 9a Microfotografía tomada a 1,500 X a muestra resina Z350 (3) en tercio cervical. D = dentina, GAP = Espacio, R = Resina. Unión resina-dentina.
Los resultados de las tinciones de Brown and Brenn de los especímenes (tomados al azar) mostraron contaminación bacteriana en los dientes G2, G6, G20, Z12, Z14, Z8, V10, V7, V8, R16, R13. En la Figura 10 se observa la penetración bacteriana a través de los túbulos dentinarios de la muestra de Guttaflow (2) sin restauración coronal.

Figura 10 Fotografía tomada del microscopio óptico Olympus Ax70 mod. Provis. Se observa la penetración bacteriana a través de los túbulos dentinarios en muestra de Guttaflow (2) sin restauración coronal campo claro a 250 X. C = conducto radicular EF = Enterococcus faecalis, TD = Túbulos dentinarios.
La muestra IRM (8) presenta poca penetración bacteriana dentro de los túbulos dentinarios ( Figura 10a).

Figura 10a Fotografía tomada del microscopio óptico. Se observan escasas bacterias penetrando en túbulos dentinarios en muestra de IRM (8) campo claro a 250 X. GF = Guttaflow, C = conducto radicular, TD = Túbulo dentinario, EF = Enterococcus faecalis.
Penetración de las bacterias en túbulos dentinarios en Vitremer (8), Figura 10b

Figura 10b Fotografía tomada del microscopio. Se observa la penetración bacteriana a través de los túbulos dentinarios en muestra de Vitremer (8) campo claro a 250 X. TD = Túbulos dentinarios, EF = Enterococcus faecalis, GF = Guttaflow.
Penetración bacteriana en muestra de resina Z350 (16) en donde no hubo ennegrecimiento (filtración bacteriana) sin embargo se observan múltiples bacterias en tercio medio y apical dentro del conducto radicular ( Figura 10c).
Discusión
El pronóstico a largo plazo del tratamiento de conductos radiculares depende del adecuado sellado y mantenimiento de la restauración para prevenir la recontaminación bacteriana del sistema de conductos radiculares.20-22 La gutapercha y el sellador representan una barrera al paso de las bacterias y sus productos dentro del sistema de conductos radiculares.23-25
Las diferencias en la filtración bacteriana del grupo IRM en comparación con Vitremer y Guttaflow probablemente se deban a la capacidad bactericida que tiene el eugenol.26 Por otro lado, Vitremer según autores como Attin y cols.27 y Zaia y cols.28 reportan una contracción en la polimerización del material ocasionada por la diferencia en la expansión térmica entre la estructura dental y el ionómero modificado. Además de que la adhesión a las paredes de la cavidad pudo haberse roto en la interfase de la restauración y el diente, llevando a una deshidratación y posteriormente la filtración. En este estudio, los dientes obturados con material provisional Vitremer presentaron filtración después del día treinta y dos, por lo que podemos mencionar que es un buen material coronal provisional pero deberá ser usado como máximo un mes.
Los resultados muestran sin duda que la resina Z350 cumplió con los requerimientos de una adecuada restauración coronal, sin embargo es preciso mencionar que las tinciones de Brown and Brenn realizadas a los dientes de este grupo (R13 y R16) mostraron contaminación bacteriana ( Figura 10c)a través de la longitud del conducto, encontrándose menos bacterias en el tercio medio que en el cervical, lo que confirman los estudios realizados por Pisano,4 Torabinejad,25 Magura,26 Khayat23, Balto2, Chailertvanitkul29, Siqueira30 en donde se menciona la contaminación del sistema de conductos radiculares de dientes obturados en aproximadamente un mes. Es importante mencionar que el grupo de resina Z350 con más tiempo de exposición a las bacterias, pudiera haber filtrado y haber presentado ennegrecimiento como en los otros grupos.
Se utilizó E. faecalis por ser de las principales bacterias encontradas en conductos radiculares con pato logia periapical, siendo el responsable del 80 al 90% de los fracasos en el tratamiento de conductos. Su importancia en este tipo de infecciones está dada por su capacidad de sobrevivir en el conducto radicular como monoinfección y a su eficiente bomba de protones para controlar su pH interno.31,12
En este estudio se utilizó agar semisólido Enterococosel™ (BBL), que es una variante del agar bilis esculina y es utilizado para la selección de Enterococos, la bacteria en este medio desarrolla un ennegrecimiento visible en la zona de filtración debido a la actividad metabólica de las bacterias sobre la esculina y su posterior reacción con el citrato férrico del medio, encomparación con otros estudios reportados por Monticelli,19 Fathi32 en los que se utiliza un medio liquido en el que se determina la filtración en el momento de turbidez del mismo, variable que en nuestro estudio fue controlada, a su vez por la colocación de aceite mineral en el agar bilis esculina y fue realizada para disminuir la difusión de oxigeno y evitar la sequedad del medio.
El sellador Guttaflow basado en una matriz de polidimetilsiloxano se puede expander ligeramente durante el endurecimiento, mejorando la adaptación a las paredes de la dentina. Este fenómeno puede ser benéfico en el tercio apical de la raíz donde el cono maestro tiene una mejor adaptación a la conformación del conducto.33
La microscopia electrónica realizada a los dientes obturados con Guttaflow indicaron que existe la presencia de «gaps» (espacios) entre el material de obturación y el conducto radicular, pero no de «tags» (uniones) por lo que el material Guttaflow no posee adhesión ni adaptación al conducto radicular en la longitud total del mismo, situación contraria a la mencionada por Elayoutti y cols.33 y el fabricante del producto, donde al parecer el Guttaflow presenta una buena adaptación a las paredes del conducto por la fácil manipulación y aplicación del material. De acuerdo a los «gaps» observados en las muestras analizadas al microscopio electrónico de barrido y al tamaño de la cepa de Enterococcus faecalis con diámetro de 0.5 a 1 µm hace suponer que las bacterias penetraron con mucha facilidad en la longitud del conducto radicular, causando el ennegrecimiento del medio (filtración bacteriana).
Conclusiones
El material de restauración provisional que no presentó filtración bacteriana fue la resina Z350; IRM presentó menor grado de microfiltración y Vitremer fue el que mayor grado de microfiltración presentó.
El material Guttaflow para la obturación de conductos, cuando no se coloca un sellado coronal presenta filtración a los seis días, lo que sin duda nos lleva a concluir que es necesaria la colocación de un material de restauración provisional para prevenir la contaminación bacteriana.
De acuerdo a los resultados obtenidos en este estudio, concluimos que el sistema de conductos radiculares se contamina aproximadamente al mes y diez días según el promedio de los materiales de restauración provisional usados, por lo tanto, la repetición del tratamiento de conductos debería ser manejada antes del mes de exposición a la cavidad oral.
Debido a que la mayoría de las evoluciones no satisfactorias en endodoncia se deben a la presencia de bacterias en el conducto radicular, es importante conocer el grado de microfiltración bacteriana de los materiales provisionales más utilizados como restauración coronal, con el fin de escoger el material más adecuado en la práctica, disminuirlaincidencia| de filtración bacteriana coronal y de esta manera aumentar la tasa de éxito en los tratamientos.











 nueva página del texto (beta)
nueva página del texto (beta)